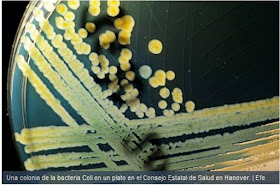

A veces surgen debates muy polémicos sobre hasta que punto es positivo hacer público el conocimiento. Los científicos esperamos que nuestros descubrimientos puedan utilizarse para salvar vidas, por eso nos sorprende que alguien pueda pensar en el sentido inverso. Sin embargo, parace que todas las precauciones son pocas cunado está sobre la mesa un descubrimiento que puede convertirse en un arma letal si cae en manos de quien no debiera. Es el caso de la noticia que destaca El Pais, según la cual Science veta la publicación de los datos precisos obtenidos por virólogos sobre los determinantes moleculares que pueden ser responsables de un salto de especie en la temida gripe aviar causada por el Influenzavirus H5N1. El artículo que menciona esta noticia no está aún publicado. Mas vale prevenir.
Por cierto, hablando de virus... Los que hayan visto hoy el telediario de la 1 en RTVE habrán visto una noticia reivindicando el futuro de la Biotecnología. Sin embargo, citando ejemplos paradigmáticos de los hitos biotecnológicos han nombrado la vacuna de la hepatitis C, cuando probablemente se referían a la hepatitis B.
Son invisibles, pero están en todas partes. Para nuestro beneficio o perjuicio continuamente interaccionamos con los microorganismos. Por eso los medios de comunicación hablan de ellos a menudo. Pero no siempre con rigor. El GRUPO ESPECIALIZADO en DOCENCIA y DIFUSIÓN de la SOCIEDAD ESPAÑOLA DE MICROBIOLOGÍA (D+D SEM) mantiene este blog con el objetivo de recopilar y comentar la información sobre los microorganismos que los medios en castellano transmiten a la sociedad.
martes, 20 de diciembre de 2011
jueves, 8 de diciembre de 2011
El ECDC da por terminado el brote de malaria en Grecia
miércoles, 7 de diciembre de 2011
Vacuna contra el virus Ébola eficaz en ratones
En el diario "El País" se hacen eco de un artículo publicado en el PNAS sobre la elaboración de una vacuna contra el virus Ébola. La vacuna ha sido probada en ratones y se ha basado en la producción de una fusión entre una glicoproteína del virus y un anticuerpo monoclonal que reconoce a esa proteína. De esa forma se forman inmunocomplejos que activan al sistema inmune.
martes, 6 de diciembre de 2011
Un flavonoide inhibidor de la entrada del virus de la Hepatitis C
En el periódico "ABC" realizan un resumen de un artículo publicado en la revista Hepatology en el que muestran que un flavonoide presente en el te verde, la epigalocatequina-3-galato (EGCG), inhibe la entrada del virus de la hepatitis C a las células del hígado. Esto puede tener aplicaciones en el trasplante hepático, pues puede prevenir infecciones. Desgraciadamente el redactor de la noticia se ha dejado llevar por el sensacionalismo y ha titulado el artículo de la siguiente manera.
El té verde puede prevenir la infección de hepatitis C
Lo que puede inducir a mucha gente a creer que consumir té va a prevenir la infección. Y no es así. El trabajo se ha realizado con ese flavonoide concentrado, no con té verde.
jueves, 1 de diciembre de 2011
Día Mundial de la lucha contra el SIDA
El 1 de diciembre es el día mundial de la lucha contra el SIDA, así que todos los periódicos publican una o varias noticias sobre el tema, sobre todo en el aspecto social de la enfermedad. Repasémoslas
En el "ABC" encontramos la única noticia que hace referencia a un artículo científico:
- "«Superratones» inmunes frente al VIH" en el que se resume los resultados de un artículo publicado en Nature
- "Las asociaciones denuncian los recortes en la prevención y atención del SIDA"
- "Carla Bruni: «No bajéis la guardia frente al sida»"
En "El Mundo"
- "China alerta de la rápida expansión del VIH entre personas mayores"
- "Seis años después, una madre con VIH y una hija sana"
- "Winstone Zulu: Adios a la cara más conocida del SIDA en África"
- "Un manifiesto para salvar a las ONG del SIDA"
En "El País"
En "20 minutos"
- "Las muertes por sida en el mundo disminuyeron un 22% en los últimos cinco años"
- "Los científicos españoles, centrados en hallar una vacuna y medicamentos contra el VIH"
miércoles, 30 de noviembre de 2011
Informe Epidemia SIDA: el problema del retraso en el diagnóstico
Como mañana es el día mundial de la lucha contra el SIDA, en el "ABC" dan la noticia de la presentación del informe sobre la epidemia de SIDA en nuestro país y destaca el dato preocupante de que un 45% de los diagnósticos fueron tardíos, lo que significa que la enfermedad se encuentra muy avanzada y puede tener un peor tratamiento.
En "El País" también han dedicado una columna a tan preocupante problema
Lucha contra el SIDA
En los últimos días han aparecido varias noticias realizadas con el SIDA en el periódico "El Mundo".
El primero es sobre el proyecto para la "Circuncisión masiva en 13 países africanos. En la revista PLoS Medicine han dedicado una sección con nueve artículos para explicar que el objetivo de la campaña es circuncidar para 2015 al 80% de los varones entre 15 y 49 años de Botsuana, Kenia, Lesotho, Malawi, Mozambique, Namibia, Ruanda, Sudáfrica, Suazilandia, Tanzania, Uganda, Zambia y Zimbabue. Se estima que para cumlir esa meta se necesitan hacer 20,3 millones de circuncisiones en los próximos cuatro años.
El segundo de los artículos es sobre el problema social que significa ser discriminado por tener SIDA. Por ello se va a lanzar la "Campaña No discriminación por VIH y sida" a nivel nacional.
Finalmente una mala noticia. Y es que el gel vaginal que contiene el antiviral tenofivir y que había mostrado resultados prometedores podría no ser tan efectivo como se pensaba. Estos por lo menos son los resultados más recientes realizados ocn un número mayor de personas que los estudios anteriores.
martes, 29 de noviembre de 2011
Ponga una bioluz en su casa
En el "ABC" aparece una curiosa noticia sobre un producto de la compañía Philips basado en la bioluminiscencia bacteriana. Los cultivos bacterianos se alimentan gracias al metano producido en un digestor anaeróbico mantenido gracias a los desechos del hogar. Este diseño es parte del proyecto "Microbial Home".
lunes, 28 de noviembre de 2011
Biogeografía microbiana de las superficies de los aseos públicos
En el periódico "ABC" hacen un resumen del artículo de tan curioso título aparecido en la revista PLoS ONE. Según los autores, el objetivo del trabajo es muy relevante para el campo de la salud pública, ya que el intercambio de bacterias en las superficies de los edificios puede representar una importante vía de transmisión de patógenos entre las personas
El grupo N del virus VIH llega a Francia
En el periódico "El Mundo" resumen un artículo publicado en la revista "The Lancet" en el que se describe el primer caso europeo de una persona infectada con la variente N del virus VIH que causa el SIDA. Dicha variante hasta ahora se había detectado solamente en Camerún. La persona había realizado un viaje a Togo donde se infectó.
viernes, 25 de noviembre de 2011
Mi lucha a muerte con la E. coli
Es es el titular de la entrevista realizada a Miguel Txoperena que aparece en el diario "ABC". Mikel fue uno de los dos españoles afectados por el brote de E. coli Enterohemorragica sucedido en Alemania hace 6 meses.
jueves, 24 de noviembre de 2011
Entrevista a Andrés Canut sobre la "crisis del pepino"
Andrés Canut es jefe de Microbiología en el Hospital de Santiago Apostol de Vitoria y recientemente fue entrevistado por el periódico "El Correo" con motivo de un seminario titulado "La crisis del pepino. ¿Los productos naturales son seguros?" en el que desmitificaba las supuestas bondades de muchos productos "bio" y "eco", sobre todo en el aspecto microbiológico.
miércoles, 23 de noviembre de 2011
Fallece Lynn Margulis
Hoy los diarios traen una mala noticia para los microbiólogos que no tiene que ver esta vez con los recortes en los presupuestos de investigación: La desaparición repentina de Lynn Margulis, una de las leyendasde la ecología y evolución en la Tierra y, en concreto, del papel de los microorganismos en ella. La noticia se puede leer de momento en El Mundo y ABC.
Foto. Tusquets
Foto. Tusquets
lunes, 21 de noviembre de 2011
Informe ONUSIDA 2011
En el periódico "El Mundo" recogen el resumen del último informe ONUSIDA. La noticia se acompaña de un gráfico interactivo que indica los nuevos casos y los fallecimientos por continentes
La misma noticia en "El País" y en "ABC"
sábado, 19 de noviembre de 2011
La vacuna contra el papiloma llegará a los países pobres
En el periódico "El Mundo" informan que la Alianza Global para Vacunas e Inmunización (GAVI) ha accedido a financiar y llevar a los páises pobres la vacuna contra el virus del papiloma humano (VPH), responsable del cáncer de cuello de útero
viernes, 18 de noviembre de 2011
Día Europeo para el Uso Prudente de los Antibióticos
Hoy se celebra el Día Europeo para el Uso Prudente de los Antibióticos así que lógicamente diversos medios dedican en sus secciones de Salud algún artículo a dicho asunto.
En el "ABC" el titular transmite algo de preocupación: Infecciones sin tratamiento, escenario posible. La noticia está ilustrada con una imagen de Pseudomonas aeruginosa, aunque parece que está retocada para resultar más espectacular (y no me refiero al falso color). En el texto hacen referencia al artículo publicado por Laura Piddock en The Lancet Infectious Diseases
En "El Mundo" titulan Europa se preocupa por el abuso de los antibióticos y nos hablan del plan de la Comisión Europea para que en los próximos cinco años los estados miembros asuman más esfuerzos en la lucha contra la resistencia a los antibióticos
Finalmente, aquí dejo un link del Ministerio de Sanidad con más información
jueves, 17 de noviembre de 2011
Nuevo fármaco contra la tuberculosis
En el periódico "El Mundo" aparece la noticia de que se van a iniciar los estudios de Fase III del antibiótico moxifloxacino para el tratamiento de la tuberculosis. Esta fluoroquinolona ya se usaba para otros tratamientos, pero parece que es bastante efectiva en la terapia antituberculosa, llegando a reducir hasta en un tercio la duración de los tratamientos.
Continúa la escasez de medicamento para la enfermedad de Chagas
Hace exactamente un mes ya comentamos en este blog la preocupante noticia de la escasez del medicamento benznidazol, uno de los medicamentos utilizados en el tratamiento de la enfermedad de Chagas. Esta vez es "El Mundo" el que vuelve a traer la noticia, haciéndose eco de una carta publicada en la revista JAMA y explicando cómo se ha llegado a la situación actual.
martes, 15 de noviembre de 2011
Proyectos financiados vía aportaciones voluntarias por la web
En tiempos difíciles hay que saber buscarse las castañas. En el periódico "El Mundo" aparece una noticia sobre como una serie de grupos de investigación, entre los que se encuentran tres españoles, buscan financiación a través de la web. Dos de los proyectos presentados tiene que ver con los microorganismos. Uno de ellos pretende usar a las levaduras como modelo para el estudio del cáncer:
El otro es sobre el aprovechamiento del alga unicelular Chlamydomonas para producir biocombustibles.
El otro es sobre el aprovechamiento del alga unicelular Chlamydomonas para producir biocombustibles.
De cómo convertir a una periodista en una epidemióloga
En el periódico "ABC" publican una interesante entrevista realizada a Maryn McKenna, periodista especializada en divulgación científica, sobre todo en temas de salud pública. Hace un año publicó un libro titulado "Superbug, the fatal menace of MRSA" dedicado al problema del Staphylococcus aureus resistente a meticilina, que se ha convertido en un best-seller. Ahora ha publicado un segundo libro titulado "Beating back the devil" dedicado a los investigadores del CDC de Atlanta.
Sin embargo parece que al "ABC" no le ha parecido lo suficientemente llamativa, así que ha adornado un poco el tema. El primero el titular:La naturaleza es el mayor bioterrorista. La frase es muy buena pero no es de Maryn McKenna, es del Doctor Stephen Morse. El segundo lo encontramos en el pie de foto que presenta a la periodista como una experta en epidemiología. No dudo de sus conocimientos en el campo adquiridos a través de su experiencia, pero se me antoja que dicho mérito es exagerado si tenemos en cuenta que según su propia página web no ha hecho ninguna carrera en el área de ciencias de la salud y ni ella misma se presenta como tal.
lunes, 14 de noviembre de 2011
Limpieza dental y salud cardiaca
En el periódico "El Mundo" se hacen eco de diversos estudios presentados en el último Congreso de la Asociación Americana del Corazón sobre el vínculo entre la higiene bucodental y la posibilidad de sufrir un infarto. En el trabajo se siguieron durante siete años a más de 100.000 participantes sin ningún problema coronario al inicio del estudio. Al finalizar el mismo se encontró que en aquellos que se hacían una limpieza o un raspado profesional disminuían las posibilidades de tener un ataque al corazón
domingo, 13 de noviembre de 2011
Informe epidemiológico del ECDC
En el periódico "El Mundo" se hacen eco de la publicación del informe epidemiológico 2011 del ECDC. En la noticia se destaca la preocupación por el aumento de la resistencias a los antibióticos, el número de brotes de sarampión (probablemente debido a los movimientos antivacunas), la incidencia de las infecciones por clamidia, el numero de casos de tuberculosis y el problema de salud pública que supone la infección con VIH.
viernes, 11 de noviembre de 2011
Estudios sobre el tratamiento de la neumonía infantil en el hogar realizado en Pakistan.
En el periódico "El Mundo" recogen el resumen del estudio publicado en The Lancet en el que muestran que la atención de los niños en el domicilio podría proporcionar más beneficios que el protocolo de atención convencional, que hace necesaria la atención hospitalaria.
Ante la aparición de síntomas graves de neumonía, parte de estos niños siguieron el protocolo estandarizado de ingreso hospitalario y tratamiento con cotrimoxazol, mientras que el resto fue atendido en sus casas y se les administró una dosis diaria de amoxicilina oral durante cinco días.
Actualización: La misma noticia en el "ABC"
jueves, 10 de noviembre de 2011
Coinfección de virus de gripe estacional (H3N2) y virus pandémico (H1N1),
En el periódico "ABC" hacen un buen resumen el trabajo publicado en la revista American Journal of Tropical Medicine and Hygiene sobre un par de casos de coinfección con virus pandémico gripal H1N1 y virus gripal H3N2. Aunque en el titular del periódico se advierte de que este suceso es "poco frecuente", en el texto también previene de que hay que estar vigilantes pues existe la posibilidad de que puedan darse nuevas combinaciones de virus gripales.
miércoles, 9 de noviembre de 2011
Estudio piloto: Una vacuna basada en el virus de viruela modificado para tratar el cáncer metastásico de mama y de ovario
En el diario "ABC" resumen los resultados de un estudio piloto publicado en la revista Clinical Cancer Research sobre el uso de una vacuna basada en el virus viruela para tratar cánceres. En el estudio han participado 26 pacientes.
martes, 8 de noviembre de 2011
III Congreso Nacional GeSIDA
En "El País" aparece una columna escrita Pere Domingo sobre los retos pendientes del VIH que serán tratados en el III Congreso Nacional GeSIDA.
lunes, 7 de noviembre de 2011
Una nariz electrónica para oler la tuberculosis
Ese es el titular de la noticia aparecida en "El Mundo" que describe la colaboración entre un grupo investigador de Nueva Delhi y la empresa estadounidense Next Dimension para desarrollar lo que se conoce como una e-nose capaz de detectar una serie de moléculas presentes en el aliento y que revelan la presencia de la enfermedad.
El artículo tiene un pequeño gazapo. Afirma que la tuberculosis es la segunda enfermedad infecciosa más letal en el mundo, sólo por detrás del SIDA. En realidad. de acuerdo con la OMS, las enfermedades infecciosas más letales son las infecciones respiratorias seguidas de las diarreas.
Actualización: la noticia también ha sido recogida en el "ABC", donde informan que el dispositivo también podría servir para detectar el cáncer.
Actualización: la noticia también ha sido recogida en el "ABC", donde informan que el dispositivo también podría servir para detectar el cáncer.
Aumento de las enfermedades de transmisión sexual
viernes, 4 de noviembre de 2011
Identificado el receptor que explicaría la propagación del sarampión
El virus del sarampión es muy contagioso. Su vía de entrada son los macrófagos y las células dendríticas de las vías respiratorias. Una vez dentro de ellos llega al sistema linfático y se disemina por todo el organismo. Pero el virus necesita volver al sistema respiratorio para propagarse. En el periódico "ABC" se hacen eco del artículo publicado en Nature en el que han identificado a la proteína nectina-4, una proteína localizada en las uniones intercelulares, como el receptor que reconoce el virus para volver a las vías respiratorias y propagarse.
jueves, 3 de noviembre de 2011
Brote de malaria en Grecia
A perro flaco todo son pulgas. En "El País" aparece la noticia de que 61 personas en cinco prefecturas han contraído la dolencia en el tercer año consecutivo. 33 de ellas son casos autóctonos, pues nunca han abandonado el país.
miércoles, 2 de noviembre de 2011
USB con luz germicida para depurar el agua
En el medio on-line "Libertad Digital" se hacen eco del desarrollo de un dispositivo que mediante una luz ultravioleta puede depurar el agua. La novedad es que esta luz tiene una conexión USB. El artilugio ha sido desarrollado por la compañía Steripen.
Sin embargo lo más llamativo es que el texto de la noticia está lleno de gazapos, algunos típicos como el de los nombres de los microorganismos. Pero otros realmente llamativos como asegurar que la luz germicida es verde, y que ¡el dispositivo puede usarse como linterna!
martes, 1 de noviembre de 2011
Reducción en el uso de antibióticos para frenar la aparición de resistencias
En el diario "20 minutos" aparece la noticia de que el Parlamento Europeo ha pedido la reducción en el uso de antibióticos para así evitar la proliferación de resistencias bacterianas a los mismos. La resolución no es vinculante, pero al menos es un paso en la buena dirección.
Liberación de mosquitos transgénicos para luchar contra el dengue
Esta noticia ya ha aparecido anteriormente en este blog, pero la que trae hoy en "El País" hace referencia a los resultados del estudio realizado en las islas Gran Caimán y que ha sido publicado en Nature Biotechnology. La noticia contiene el típico error de nomenclatura biológica, pero no por ello no hay que dejar de indicarlos. ¿Por qué les costará tanto a los periodistas escribir correctamente el nombre de las especies? C. hominivorax es la mosca Cochliomyia hominivorax. Adicionalmente, el texto de la noticia contiene unos cuantos errores de redacción que dificultan su comprensión. Véase la imagen inferior
lunes, 31 de octubre de 2011
Resultados del programa Bacteriemia Zero: Disminuyen a la mitad las infecciones por catéteres
En el periódico "El País" aparece el resumen de los primeros resultados del programa Bacteriemia Zero. El programa perseguía la estandarización de medidas preventivas en las UCIs. Entre las medidas se encontraban el lavado de manos, cubrir por completo al paciente con trapos estériles al implantar la sonda o cambiar el antiséptico -se utiliza clorhexidina en vez de povidona.
domingo, 30 de octubre de 2011
Brote de listeriosis en los Estados Unidos debido a unos melones contaminados
El pasado mes de septiembre se originó un brote de listeriosis debido a una partida de melones contaminados con la bacteria Listria monocitogenes. Los melones eran de la variedad cantalope y provenían de la industria Jensen Farm. La noticia aparece en "ABC" y en "El Mundo". En ambos podemos leer que según el CDC, han muerto 28 personas y 133 continúan enfermas.
viernes, 28 de octubre de 2011
EE UU recomienda vacunar a los niños varones de 11 y 12 años contra el VPH
Noticia aparecida en el "El País" que resume la recomendación lanzada por el CDC (Center for Diseases Control). Una mayor cobertura de la noticia puede encontrarse en el New York Times y en la CNN.
Groenlandia y el origen de la vida en la Tierra
En el "ABC" resumen un artículo publicado en la revista PNAS sobre la descripción del posible nicho donde pudo surgir la vida de este planeta. Se trata del cinturón supracortical de Isua, en Groenlandia. Al parecer en la roca serpentinita de los volcanes de esa zona se encuentran fluidos con condiciones reductoras y alto pH que podrían haber permitido la estabilización de los aminoácidos que se formaran de manera abiogénica.
El artículo contiene un divertido gazapo. Han traducido black smokers por fumadores negros en lugar de fumarolas negras.
Sanatorios para aislar a tuberculosos
En el periódico "El Mundo" aparece la noticia de que un grupo de expertos de la OMS ha firmado una carta que se ha publicado en la revista The Lancet para apoyar el retorno de los sanatorios para aislar a los enfermos con tuberculosis multirresistente (MDR) como una forma de controlar la diseminación de la enfermedad.
jueves, 27 de octubre de 2011
Yogures con probióticos y microbiota intestinal ¿beneficios para la salud?
En el periódico "El País" aparece el siguiente titular:
Los yogures con probióticos no consiguen el beneplácito científico
Aunque luego en el subtítulo matizan: Los datos de un ensayo no permiten asegurar que sean beneficiosos, aunque alteran la digestión de azúcares.
Porque si leemos el abstract del artículo publicado en Science Translational Medicine, o el resumen del estudio (en inglés) más bien el subtítulo debería sustituir al titular. Efectivamente no se ha demostrado que sean beneficiosos para la salud, (tampoco lo encontró otro estudio de la Agencia Europea de Seguridad Alimentaria), pero el titular de la noticia me parece excesivamente categórico, sobre todo porque evaluar los efectos saludables no parece que fuera el objetivo del trabajo. Las principales conclusiones del estudio es que no han encontrado diferencias en la composición del microbioma intestinal tras la ingesta continuada de yogures, pero sí han encontrado cambios metabólicos y transcripcionales que reflejan como el microbioma se adapta a la llegada de nuevas especies.
En mi opinión, el principal logro es lo que dicen los autores del artículo al final del resumen: Estos experimentos muestran una línea de investigación a seguir para el estudio de los efectos de los productos lácteos fermentados sobre el microbioma humano.
Actualización: la noticia también ha aparecido en "ABC" y en "El Mundo". El resumen de este último medio explica de manera más precisa el objetivo del trabajo.
miércoles, 26 de octubre de 2011
Hoy la noticia es este blog. Cumplimos 1 año
Pues sí. Hace exactamente un año que Victor creó este blog dedicado a la presencia de la microbiología en los medios de comunicación. Aunque fundamentalmente nos hemos centrado en las noticias de las prensa escrita, ya que son las más fáciles de acceder por internet, también han aparecido referencias a otros medios como la televisión, la radio e incluso las series televisivas.
A lo largo de estas 175 entradas han aparecido una gran variedad de noticias, casi todas ellas provenientes de los periódicos "ABC", "El País" y "El Mundo". Hay que reconocer que este último medio es el más "microbiológico" ya que es el que más veces ha aparecido en este blog, probablemente porque tiene una sección dedicada en exclusiva al VIH en su apartado de Salud.
Y como dice el refrán: "el que tiene boca se equivoca". En opinión de los responsables del grupo de trabajo el periódico "El Mundo" es el merecedor del galardón: Gazapo Microbiológico, por la fotografía titulada "E. coli en el plato"
Gracias por leernos. Seguiremos trabajando
martes, 25 de octubre de 2011
Todo es relativo: Amebas gigantescas de 10 cm en la fosa de las Marianas
En el "ABC" encontramos un resumen de los recientes hallazgos de la Scripps Oceanic Institution en la Fosa de las Marianas. Han encontrado un tipo de amebas de 10 cm de tamaño pertenecientes a la clase Xenophyophorea, un tipo de foraminífero. La noticia contiene un link al vídeo que se muestra abajo y donde pueden verse a estas criaturas. El periódico indica que serían las criaturas unicelulares más grandes que existen. Bueno, yo recuerdo mis tiempos de instituto que nos enseñaban que la Acetabularia podía llegar a los 10 cm de tamaño. De todas formas, aquí dejo un link del debate de ¿cuál es la célula más grande? (en inglés).
Rotavirus, mortalidad infantil y sensacionalismo
Casi medio millón de niños mueren por diarreas víricas
Ese es el estremecedor titular de la noticia aparecida en "El Mundo" para referirse al trabajo aparecido en The Lancet Infectious Diseases sobre la estimación de mortalidad debida a las infecciones infantiles por rotavirus durante el año 2008. Es decir, el titular correcto debería haber sido:
Casi medio millón de niños murieron en el año 2008 por diarreas víricas
Por qué es importante este dato. Pues porque así se tiene una cifra con la que comparar y saber si las campañas de vacunación que se están llevando a cabo a nivel mundial son realmente efectiva
lunes, 24 de octubre de 2011
Exposición sobre la pandemia de tuberculosis en la estación de Chamartin
En "El Mundo" informan de la apertura en la estación madrileña de Chamartín de una exposición fotográfica titulada "El rostro de la tuberculosis". La noticia contiene una pequeña fotogalería.
domingo, 23 de octubre de 2011
Redes sociales y epidemias
La película "Contagio" parece haber suscitado un interesante debate sobre la relación entre redes sociales y las epidemias. En el periódico "El Mundo" se hace un resumen sobre diversos estudios que se están realizando para comprobar si las actitudes sociales -reflejadas en los comentarios que se vierten en servicios como Twitter- influyen en la propagación de enfermedades y problemas sanitarios, como la obesidad o las propias campañas de vacunación.
sábado, 22 de octubre de 2011
El tenofovir, un antiviral contra el VIH usado en geles vaginales, también inhibe al virus del herpes
En mi opinión, ese debería haber sido el titular de la noticia aparecida en "El Mundo", pero han preferido uno un más escueto, y confuso:Un estudio muestra el modo de acción del gel para prevenir el VIH y el herpes. El artículo resume los resultados publicados en la revista Cell Host and Microbes
viernes, 21 de octubre de 2011
China vacunó a 4,5 millones de personas contra la polio
En el periódico "El Mundo" podemos leer la preocupante noticia de que se han detectado 17 nuevos casos de polio en China y de que las autoridades están intentando controlar el brote con una masiva campaña de vacunación. El origen del brote se localizó en Pakistan, como ya hemos comentado anteriormente en este blog. La OMS estima que por cada caso del que se tiene constancia, habría otras 199 personas infectadas aunque sin síntomas.
jueves, 20 de octubre de 2011
Día de la prueba del VIH
Hoy es el día mundial de la prueba del VIH así que se ha lanzado una campaña para promocionar el test rápido de detección precoz. En el periódico "El Mundo" se recogen los detalles de dicha campaña. Según estima el Secretario del Plan Nacional sobre SIDA, un tercio de los infectados en nuestro país no saben que tienen dicha enfermedad.
miércoles, 19 de octubre de 2011
Vacuna de la malaria. Resultados de la Fase III
La noticia microbiológica del día son los esperanzadores resultados de los ensayos en Fase III de la vacuna RTS,S/AS01 contra la malaria: la inmunización reduce a la mitad el riesgo de infección en bebés de edades entre cinco y 17 meses. Los resultados han sido publicados en la revista New England Journal of Medicine. La notica es recogida en los tres periódicos principales:
"ABC": Una vacuna reduce a la mitad la malaria en niños de 5 a 17 meses. La imagen superior proviene de este periódico
"El Mundo": A un paso de la primera vacuna contra la malaria. Este artículo el que contiene más información sobre el ensayo
"El País": La vacuna contra la malaria da otro paso hacia su uso a gran escala
martes, 18 de octubre de 2011
Comunicación bacteriana y clima
En el periódico "ABC" encontramos esta noticias sobre el artículo publicado en la revista Environmental Microbiology Reports en el que se describe como las bacterias de los fondos oceánicos se comunican entre sí (el llamado quorum sensing) para aprovechar mejor las fuentes de carbono disponibles. Si el resultado se confirma probablemente tenga mucha influencia en nuestra comprensión de los ciclos biogeoquímicos y de su importancia para el clima de la Tierra.
Desgraciadamente el redactor de la noticia ha debido de utilizar el traductor Google con la nota de prensa del Woods Hole Oceanographic Institution y ni se ha molestado en comprobar el sentido. En el texto del "ABC" se lee esto:
La fuente de carbono de las partículas a las que se adhieren las bacterias es atmosférica. En concreto, dióxido de carbono, capaz de "capturar" gases de efecto invernadero.
Y en el texto original esto:
The source of carbon in the particles is atmospheric carbon dioxide, a heat-trapping greenhouse gas.
Cuya traducción es: La fuente de carbono en las partículas es el dióxido de carbono, un gas de efecto invernadero que atrapa el calor
La "microbiota" de los teléfonos móviles.
De vez en cuando aparecen en los medios de comunicación noticias un tanto alarmistas sobre la presencia de microorganismos fecales, patógenos o ambas cosas, en instrumentos o en dependencias de uso cotidiano. Esta vez nos encontramos a una de ellas en "El Mundo". El titular es "Uno de cada seis móviles está contaminado con materia fecal". En realidad lo que dicen los autores es que en 1 de cada 6 móviles de Gran Bretaña se detecta Escherichia coli de origen fecal. El estudio se ha publicado con motivo del Día Mundial del Lavado de Manos. Evidentemente es un dato preocupante, e indica que mucha gente no tiene un especial cuidado con su higiene personal (ni la de los demás) cuando va al aseo. Pero en dicho artículo también pueden leerse cosas como "en el 92% de los teléfonos y en el 82% de las manos había bacterias." Bueno, si tenemos en cuenta que las bacterias están por todas partes, y de que forman parte de nuestra microbiota, lo cierto es que me sorprende que no se haya alcanzado el 100%.
lunes, 17 de octubre de 2011
Escasez de un medicamento para combatir al mal de Chagas
En el periódico "El País" hacen un resumen de la preocupante situación a la que se ha llegado cuando ha empezado a faltar el medicamento Benznidazol utilizado en el tratamiento del mal de Chagas caudado por el protozoo Trypanosomoa cruzi